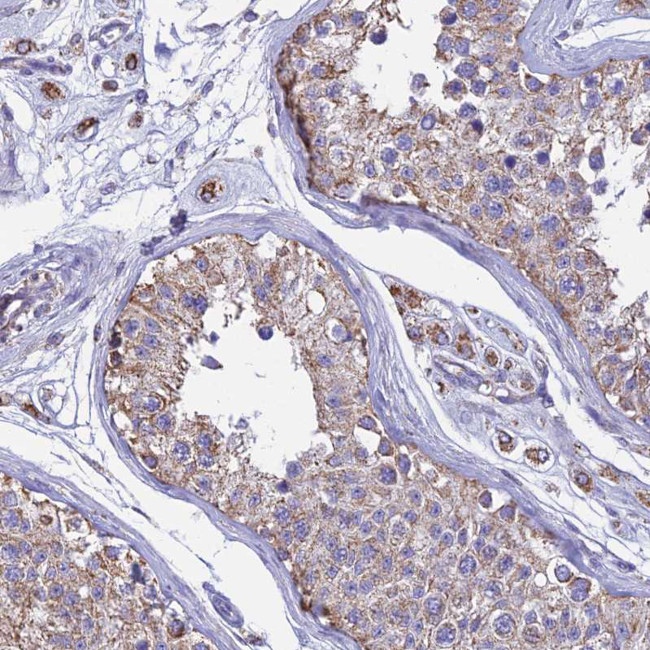
OR2W3 Antibody in Immunohistochemistry (Paraffin) (IHC (P))

Search
Invitrogen
OR2W3 Polyclonal Antibody
{{$productOrderCtrl.translations['antibody.pdp.commerceCard.promotion.promotions']}}
{{$productOrderCtrl.translations['antibody.pdp.commerceCard.promotion.viewpromo']}}
{{$productOrderCtrl.translations['antibody.pdp.commerceCard.promotion.promocode']}}: {{promo.promoCode}} {{promo.promoTitle}} {{promo.promoDescription}}. {{$productOrderCtrl.translations['antibody.pdp.commerceCard.promotion.learnmore']}}
产品信息
PA5-61043
种属反应
已发表种属
宿主/亚型
分类
类型
抗原
偶联物
形式
浓度
规格
纯化类型
保存液
内含物
保存条件
运输条件
RRID
产品详细信息
Immunogen sequence: GHHEVDHFLR EMPALIRMAC VSTVAIE
Highest antigen sequence identity to the following orthologs: Mouse - 78%, Rat - 78%.
靶标信息
Olfactory receptors interact with odorant molecules in the nose, to initiate a neuronal response that triggers the perception of a smell. The olfactory receptor proteins are members of a large family of G-protein-coupled receptors (GPCR) arising from single coding-exon genes. Olfactory receptors share a 7-transmembrane domain structure with many neurotransmitter and hormone receptors and are responsible for the recognition and G protein-mediated transduction of odorant signals. The olfactory receptor gene family is the largest in the genome. The nomenclature assigned to the olfactory receptor genes and proteins for this organism is independent of other organisms.
仅用于科研。不用于诊断过程。未经明确授权不得转售。
生物信息学
蛋白别名: Olfactory receptor 2W3; Olfactory receptor 2W8; Olfactory receptor OR1-49; olfactory receptor, family 2, subfamily W, member 3 pseudogene; olfactory receptor, family 2, subfamily W, member 8 pseudogene
基因别名: OR2W3; OR2W3P; OR2W8P; OST718
UniProt ID: (Human) Q7Z3T1
Entrez Gene ID: (Human) 343171